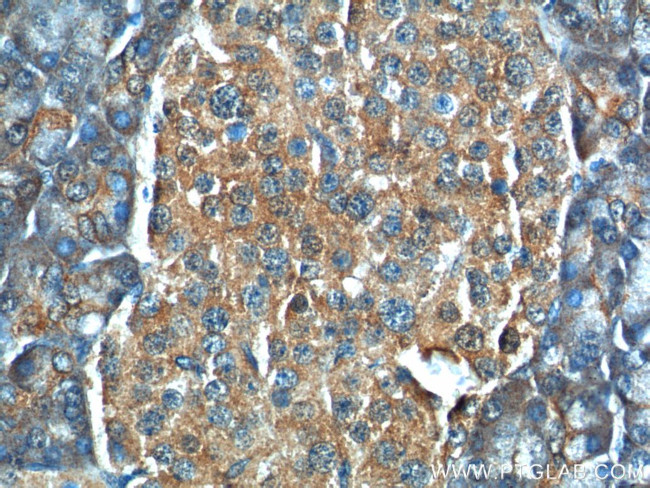
C11orf80 Antibody in Immunohistochemistry (Paraffin) (IHC (P))
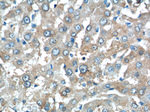
C11orf80 Antibody in Immunohistochemistry (Paraffin) (IHC (P))

Search
Proteintech
C11orf80 Polyclonal Antibody
{{$productOrderCtrl.translations['antibody.pdp.commerceCard.promotion.promotions']}}
{{$productOrderCtrl.translations['antibody.pdp.commerceCard.promotion.viewpromo']}}
{{$productOrderCtrl.translations['antibody.pdp.commerceCard.promotion.promocode']}}: {{promo.promoCode}} {{promo.promoTitle}} {{promo.promoDescription}}. {{$productOrderCtrl.translations['antibody.pdp.commerceCard.promotion.learnmore']}}
产品信息
25957-1-AP
种属反应
宿主/亚型
分类
类型
抗原
偶联物
形式
浓度
纯化类型
保存液
内含物
保存条件
运输条件
产品详细信息
Immunogen sequence: LCPSPKVSS NQLNRISSVS IFLYGPLGLP LILSTWEQPM TTFFKDTSSL VDWKKYHLCM IPNLDLNLDR DLVLPDVSYQ VESSEEDQSQ TMDPQGQTLL LFLFVDFHSA FPVQQMEIWG VYTLLTTHLN AILVESHSVV QGSIQFTVDK VLEQHHQAAK AQQKLQASLS VAVNSIMSIL TGSTRSSFRK MCLQTLQAAD TQEFRTKLHK VFREITQHQF LHHCSCEVKQ QLTLEKKDSA QGTEDAPDNS SLELLADTSG QAENKRLKRG SPRIEEMRAL RSARAPSPSE AAPRRPEATA APLTPRGREH REAHGRALAP GRASLGSRLE DVLWLQEVSN LSEWLSPSPG P (328-677 aa encoded by BC028240)
靶标信息
C11orf80 locates at the chromosome 11. It has two isoforms with MW 70-75 kDa.
仅用于科研。不用于诊断过程。未经明确授权不得转售。
篇参考文献 (0)
生物信息学
蛋白别名: putative uncharacterized protein C11orf80; TOP6B like initiator of meiotic double strand breaks; TOPOVIBL; Type 2 DNA topoisomerase 6 subunit B-like; Type 2 DNA topoisomerase VI subunit B-like; uncharacterized protein C11orf80
基因别名: C11orf80; TOP6BL; TOPOVIBL
UniProt ID: (Human) Q8N6T0
Entrez Gene ID: (Human) 79703